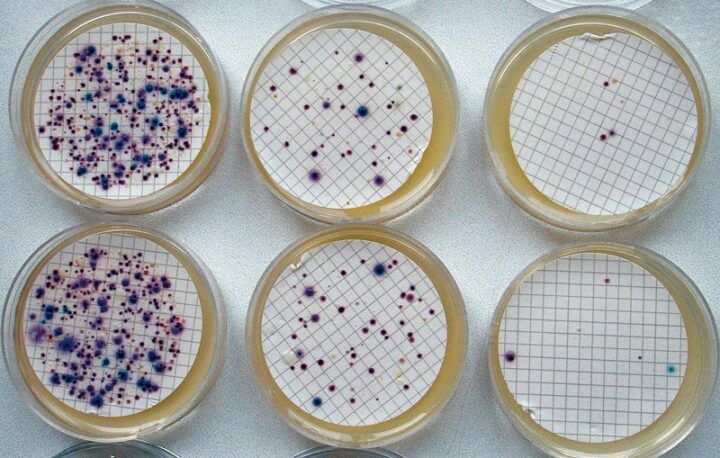
04: Escherichia coli
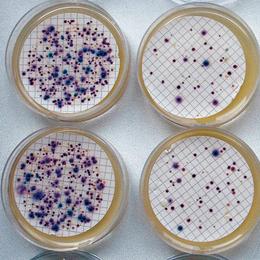

- milvit.cz
- Problémy vody
- Bakterie
Bakterie ve vodě
Ve vodním prostředí se přirozeně nachází široká řada mikroorganismů, jejichž nejpočetnější skupinou jsou bakterie. Bakterie se nachází ve vodě, zejména v blízkosti možných zdrojů znečištění. Mezi tyto zdroje patří například hnojiště, neuzavřené septiky a pole. Není však pravidlem, že bakterie můžeme najít pouze ve vodě, která má blízko ke zdroji znečištění - právě naopak. Je možné najít jisté druhy bakterií například i v již upravené pitné vodě. Nejčastější druhy bakterií ve vodě jsou potom koliformní bakterie a bakterie druhu Legionella.
Koliformní bakterie
Tento druh bakterií způsobuje nevolnosti, průjmy a zvracení. Při jejich vysokém množství ve vodě se setkáváme se zákalem, zápachem a pachutí. Pokud je ale ve vodě pouze malé množství těchto bakterií, není možné jejich přítomnost ve vodě pouhým okem rozpoznat. Tolerance přítomnosti těchto bakterií v pitné vodě je 0 KTJ/100 ml. Nejvíce rozšířeným zástupcem tohoto druhu bakterií je Escherichia coli. Pro odstranění koliformních bakteríí nabízíme produkty pro dezinfekci vody jako jsou například UV lampy a dávkovací čerpadla.
Enterokoky (fekální streptokoky)
Tento druh bakterií se ve vodě množí jen vzácně a v běžných podmínkách geologického prostředí přežívá jen velmi krátkou dobu. Enterokoci jsou proto považováni za jasný průkaz čerstvého fekálního znečištění. Pocházejí ze zažívacího traktu teplokrevných živočichů a mohou se za určitých podmínek projevovat různými zánětlivými procesy. Organické látky tohoto fekálního znečištění podporují rozvoj železitých bakterií. Jejich nepříjemnou vlastností je poměrná odolnost vůči chlorové dezinfekci vody. Důkladná a důsledná chlorace pomocí dávkovacího čerpadla je podmínkou.

Psychrofilní bakterie a Mezofilní bakterie (kultivované mikroorganismy)
Optimum růstu je u psychrofilních bakterií 22°C, u mezofilních bakterií při 36°C. Riziko, že se mohou mezi nimi vyskytnout patogenní organismy, je poměrně nízké. Jejich zvýšený počet diagnostikuje závažné znečištění vodního zdroje z vnějšího prostředí, a to buď přímo mikroorganismy nebo biologicky rozložitelnými organickými látkami, které tyto skupiny bakterií využívají ke svému životu. Tyto bakterie však nedokazují fekální znečištění, ale pouze spojitost podzemní vody se zdrojem jistého znečištění. Psychrofilní bakterie můžou souviset i s výskytem bakterií ovlivňujících koloběh železa, které se uplatňují v prostředí s obsahem organických látek. Výskyt takovýchto bakterií způsobuje zhoršené organoleptické vlastnosti vody - zákal, chuť a pach.
Bakterie Legionella Pneumophila
Vyskytuje se běžně ve všech vodách v neškodném množství, nicméně při teplotách 32-42°C se začíná intenzivně množit. Při vypití není zdraví nebezpečná, avšak pokud vnikne do plic (např. během sprchování), může způsobit onemocnění legionelózu, což je potencionálně až smrtelné onemocnění. Přítomnost této bakterie není spojena s žádným zápachem nebo pachutí. Odstranění legionelly z vody je možné pomocí dávkovacího čerpadla dávkováním Sanosilu (na rozdíl od klasického dávkovacího čerpadla dávkujícího chlor, rozdíl je pouze v náplni).

Bakterie Pseudomonas Aeruginosa
Pokud se setkáme s vysokou přítomností této bakterie ve vodě, voda bude zakalená, s přítomným zápachem a pachutí. Přítomnost běžného množství této bakterie ve vodě bude pouhému oku nepostřehnutelná. Pseudoonas způsobuje nevolnosti, průjmy a zvracení. Povolený limit této bakterie v pitné vodě je 0 KTJ/250 ml.
Klíčová slova: koliformní bakterie ve vodě, enterokoky, psychrofilní bakterie, mezofilní baterie, mikroorganismy, filtr na koliformní bakterie, koliformní bakterie ve studni, Legionella, bakterie Legionella ve vodě, Pseudomonas Aeruginosa, Pseudomonas ve vodě
Escherichia coli
Escherichia coli – nachází se ve střevní mikroflóře teplokrevných živočichů včetně člověka. Bakterie se dostávají do lidského těla prostřednictvím kontaminovaných potravin, nejčastěji ze syrového či nedostatečně tepelně opracovaného masa či masných výrobků,
mléka, ze zeleniny (růžičková kapusta, listy salátu), z kontaminované pitné vody nebo kontaktem s nakaženými zvířaty.
Přítomnost Escherichia coli v pitné vodě je nebezpečná. Lehčí forma infekce se projevuje průjmy, dehydratací. Těžké formy vedou k hospitalizaci
nemocnici a pacientovi jsou nasazena antibiotika.
Proč nakupit u nás